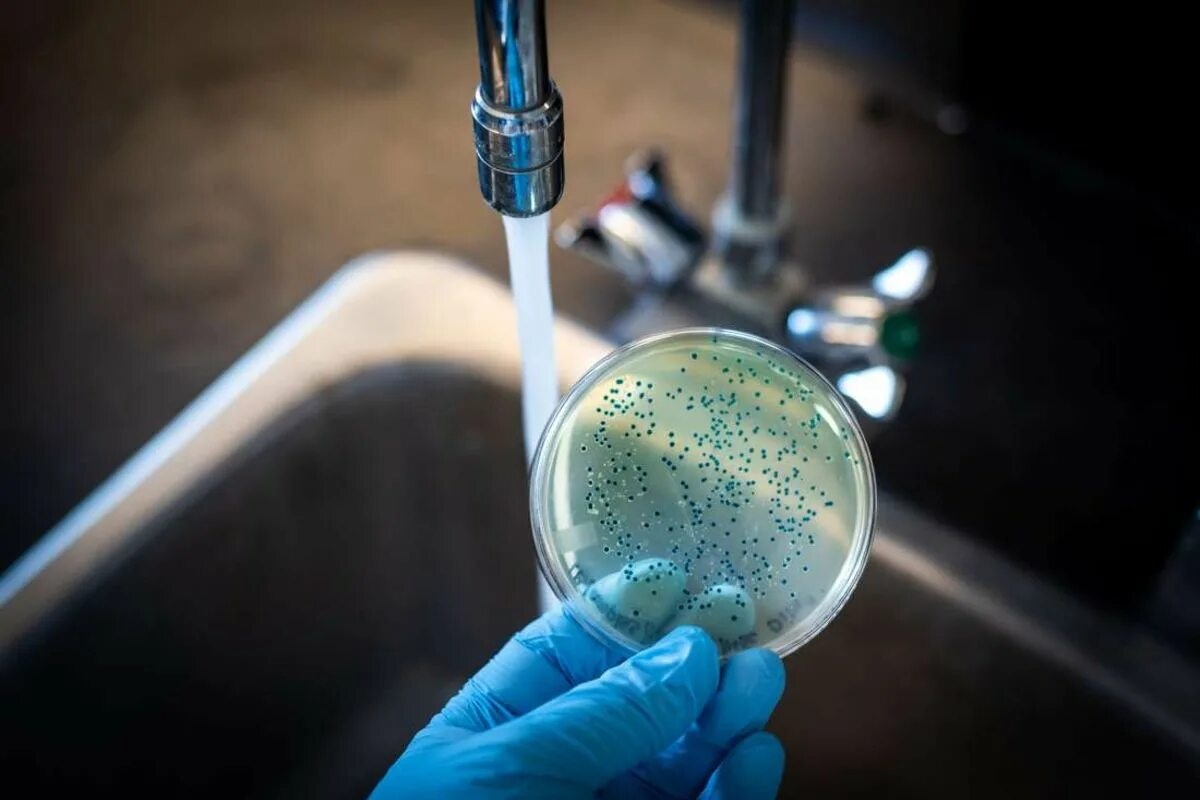
Warm water bevat veel bacteriën

We weten dat kraanwater over het algemeen drinkbaar is… maar dat is niet altijd het geval. Volgens microbiologen zou warm water zelfs ongeschikt zijn voor consumptie. Maar waarom?
Lauw water onder de 60 graden is ideaal voor de verspreiding van bacteriën. Deze bacteriën ontwikkelen zich ook snel in stilstaand water. Dit kan bijvoorbeeld gebeuren in uw leidingen of boilers. Sommige leidingen zijn echter bijzonder gevoelig voor temperatuurschommelingen. Warm water veroorzaakt dan chemische schokken die het potentieel ondrinkbaar maken.
Lauw water is het meest problematisch
Het lauwe water dat uit uw kraan komt, is het meest problematisch en kan een broeinest van bacteriën zijn. “De ideale temperatuur voor de meeste bacteriën is 37 graden, de temperatuur van het menselijk lichaam. Lauw water heeft naar schatting een temperatuur tussen 25 en 45 graden, de temperatuur waarbij bacteriën zich het snelst en het meest verspreiden en ontwikkelen. Bij lagere temperaturen kunnen ze ook groeien, maar veel langzamer”, legt Desguin Benoit, microbioloog aan de UCLouvain, uit.
Warm water is ook een risico wanneer het in uw leidingen blijft staan. Dit is vaak het geval wanneer u afwezig bent. “Wanneer u thuis bent, gebruikt u niet altijd water. Daardoor kan het water gaan stilstaan in zogenaamde dode armen. Door het stilstaande water kunnen bacteriën zich ontwikkelen. Als u op vakantie gaat of een lang weekend weg bent, is het verstandig om de waterpunten te legen”, merkt Carole Schirvel, hygiënist bij de universitaire klinieken Saint-Luc, op.
Leidingen die bacteriën overbrengen
Sommige leidingen zijn ook gevoelig voor temperatuurschommelingen en brengen eveneens bacteriën over. “Leidingen kunnen ook worden blootgesteld aan thermische en chemische schokken als gevolg van temperatuurschommelingen. In deze leidingen kunnen zogenaamde biofilms worden aangetroffen, waarin bacteriën en voedingsstoffen zich bevinden. Wanneer deze biofilms om een of andere reden uiteenspatten, kunnen ze helaas bacteriën verspreiden over het hele warmwaternetwerk”, vervolgt ze.

Het grootste risico: legionella. “Legionella veroorzaakt legionellose, een longontsteking, een bacteriële pneumonie. Bij het douchen bijvoorbeeld verspreidt het zich via de lucht en besmet het kwetsbare personen.”
De gezondheidsautoriteiten analyseren alleen het koude water van het distributienetwerk om er zeker van te zijn dat het drinkbaar is. Maar wanneer het bij u thuis aankomt, wordt het door uw eigen systeem verwarmd en bent u dus zelf verantwoordelijk voor de kwaliteit van uw warm water om besmetting te voorkomen.